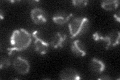
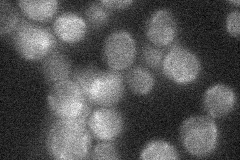
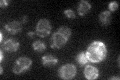

View description
Mitochondrial protein kinase involved in negative regulation of pyruvate dehydrogenase complex activity by phosphorylating the ser-133 residue of the Pda1p subunit; acts in concert with kinase Pkp2p and phosphatases Ptc5p and Ptc6p
Localization:
Intensity:
Fold change:
Significance:
-
C’ GFP library in SD
mitochondria27.35 -
N' NOP1pr-GFP in SD

cytosol24.3918 -
N' TEF2pr-mCherry in SD

below threshold7.94303 -
N' NATIVEpr-GFP in SD
below threshold19.3674 -
N' TEF2pr-VC and Cyto-VN in SD

#N/A0 -
C’ GFP library in SD+DTT

mitochondria22.640.82No -
C’ GFP library in SD+H2O2

vacuole29.841.09No -
C’ GFP library in Starvation Media
mitochondria40.731.48Yes -
C’ GFP library on the background of Pup2-DaMP

N/A -
C’ GFP library on the background of CCT mutant

N/A0N/AYes
